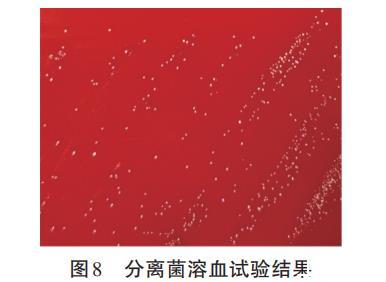

畜禽微生态制剂的优质候选:约氏乳杆菌G1的益生特性与安全谱
2.7 分离菌溶血性测定结果
分离菌溶血性测定结果见图8。结果显示,G1未产生透明或草绿色溶血环,提示该菌株不具有溶血性。
图8 分离菌的溶血性试验结果
2.8 分离菌药物敏感性试验结果
通过oCelloScope快速药敏系统对菌株G1进行连续监测分析,其药物敏感性判定结果见表2。该系统通过比较各含药孔与生长对照孔的实时生长曲线,自动判定:G1菌株对亚胺培南、氨苄西林、头孢唑啉、头孢噻吩、头孢克洛、左氧氟沙星、克林霉素、氟苯尼考、氯霉素、红霉素敏感;对青霉素和阿奇霉素为中介;对丁胺卡那和头孢西丁耐药。该结果由系统软件根据CLSI M62(2024)折点自动生成,避免了人为判读误差。
表2 分离菌药物敏感性试验结果
| 药物名称 | 抑菌圈 直径/mm | 敏感性 | 药物名称 | 抑菌圈 直径/mm | 敏感性 |
|---|---|---|---|---|---|
| 青霉素 | 26.60±1.51 | I | 克林霉素 | 23.40±0.69 | S |
| 亚胺培南 | 24.60±0.56 | S | 氟苯尼考 | 23.23±0.38 | S |
| 氨苄西林 | 23.93±0.40 | S | 丁胺卡那 | 12.53±0.55 | R |
| 头孢唑啉 | 22.03±0.83 | S | 氯霉素 | 19.73±0.40 | S |
| 头孢噻吩 | 26.03±0.96 | S | 阿奇霉素 | 14.07±0.71 | I |
| 头孢克洛 | 26.83±0.29 | S | 红霉素 | 22.03±0.91 | S |
| 左氧氟沙星 | 15.63±1.71 | S | 头孢西丁 | 10.20±0.75 | R |
注:S表示敏感,I表示中介,R表示耐药。
3 讨论
本研究从和田黑鸡肠道内容物中分离出一株约氏乳杆菌G1,通过研究其体外生物学特性,揭示其作为潜在益生菌候选株的显著优势。该菌株不仅具备优异的产酸能力、自聚集和疏水性能,还拥有良好的耐酸性、耐胆盐性及体外安全性。这些特性为开发区域性畜禽专用益生菌制剂提供了关键的科学依据。
产酸能力是乳酸菌的关键特性及评价其益生品质的重要指标之一。本研究中,G1在培养2h后即启动产酸过程,并于12h内将培养液pH值显著降低至3.8。其产酸速率与效率均优于冯鸣鹊等报道的犊牛源约氏乳杆菌分离株。这表明G1具备优良的产酸特性,具有深入研究和应用开发的潜力。
益生菌在动物体内发挥作用,首先需要在胃肠道中存活,因此菌株抵挡胃部酸和肠道中胆盐的破坏十分重要。本研究中,G1的存活率受到酸性环境、胆盐浓度及处理时间的显著影响,呈现出明确的浓度与时间依赖性。李瑞等探究双峰驼肠源约氏乳杆菌对酸的耐受能力,发现其在pH 3.0环境中存活时间不超过120min,而G1在pH3.0环境中培养4h存活率均达到了79.3%,说明G1对酸的耐受能力较强。蔡熙姮等从蓝狐肠道内容物中分离的约氏乳杆菌在3g/L胆盐条件下耐受6h,其存活率为(75.81±0.43)%,高于本研究G1菌株在相同胆盐环境下4h存活率(55.4%)。Gao等从和田黑鸡肠道中分离的乳酸菌属戊糖片球菌HBC,对酸和胆盐的耐受性明显低于在相同处理条件下G1。表明G1的胆盐耐受性较为优越。综合分析,该菌株对中等酸性和低浓度胆盐具备良好的耐受特性,为其作为益生菌候选者提供了关键依据。
益生菌需要具备肠道黏附能力,以实现其在动物肠道内的定植与繁殖,而疏水性和自聚集性可以从侧面反应乳酸菌在肠道中的定植能力。乳酸菌的疏水性通常与其表面蛋白或脂磷壁酸中的疏水结构域相关,可能促进菌体与宿主肠黏膜的初始黏附。自聚集能力的增强则表明菌株可通过细胞间相互作用形成微菌落,从而有助于在肠道内建立稳定的生态位。本试验分离的G1疏水性为(63.12±2.78)%,自聚集率为(41.19±2.26)%,与先前报道的乳酸菌疏水自聚集能力研究结果一致。表明G1具有良好的疏水自聚集能力,为其在肠道黏附提供了一定的生物学基础。
大量研究证实,乳酸菌是宿主肠道菌群中具有益生功能的关键组分,并在抑制病原菌定植与增殖方面发挥重要作用。本研究显示,G1的无细胞上清液对金黄色葡萄球菌、大肠埃希氏菌及沙门氏菌均能产生不同程度的抑菌活性,并且上清液对沙门氏菌的抑制效果优于其他两株质控菌。表明G1对革兰氏阳性菌与革兰氏阴性菌均具有广谱抑菌特性,该结果与李雪莉等的研究结果一致。同时,G1的抑菌活性呈现出明确的浓度依赖性,其最高浓度(500mg/mL)上清液所产生的抑菌圈均极显著大于较低浓度组。这一发现表明,G1在生长过程中可能分泌了具有抗菌活性的代谢产物,随着上清液浓度的提高,这些活性物质的局部浓度相应增加,从而更有效地干扰了质控菌的生长,具体机制需要进一步研究,这些发现为其作为一种潜在的益生菌或“后生元”制剂提供了重要的理论依据。
在药物敏感性方面,本研究分离菌G1对丁胺卡那和头孢西丁表现出耐药特性。丁胺卡那是氨基糖苷类抗生素,在发挥作用时需要依赖氧依赖性主动转运系统进入到细菌细胞内。许多乳酸菌,缺乏这种高效的转运系统或者其细胞膜通透性对这类药物天然较低。因此,对氨基糖苷类表现出固有耐药性在乳酸菌中较为常见。乳酸菌可表达多种β-内酰胺酶,能水解头孢西丁,因此对头孢西丁表现耐药。G1对青霉素和阿奇霉素表现为中介,其余10种试验药物均表现为敏感。同时,G1在溶血试验中未表现α或β溶血活性,符合FAO/WHO推荐的益生菌安全性标准。这一特性至关重要,因为无溶血活性排除了其破坏宿主红细胞的风险,而敏感的抗生素谱可避免耐药基因水平转移至病原菌,保障其在畜禽生产中应用的生物安全性。
4 结论
本研究从新疆地方品种和田黑鸡肠道内容物中分离出一株约氏乳杆菌G1,该菌株具有较好的耐酸、耐胆盐特性和疏水自聚集能力,同时对金黄色葡萄球菌、大肠埃希氏菌及沙门氏菌存在广谱抑制效应,其可作为畜禽益生菌开发的优质候选资源。
相关新闻推荐
1、不同温度和pH对白三叶草链格孢菌菌落生长的影响【实验结果】
3、青贮乳酸菌生长曲线、产酸和抑菌能力、抗生素耐药性测定(一)
